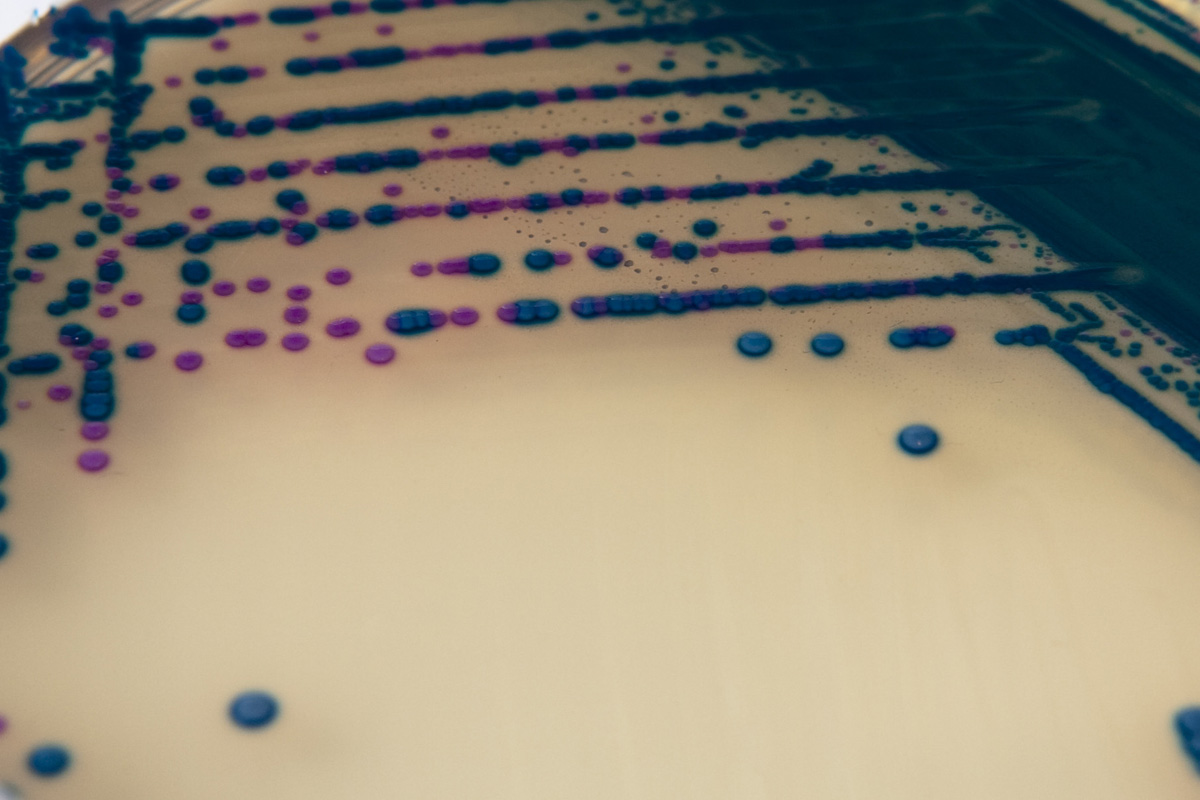

À propos du produit
Milieu chromogène pour l’isolement et l’identification présomptive de Streptococcus agalactiae.
CHROMAGAR STREP B

Milieu chromogène pour l’isolement et l’identification présomptive de Streptococcus agalactiae.